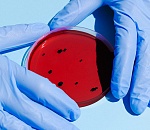
Более 7 тысяч астраханцев болеют коронавирусом прямо сейчас

Новости кратко
18:00
16:45
16:23
15:39
15:05
14:00
12:56
12:05
10:27
09:53
Астраханцы встретят новый год пробежкой
26.12
249
07:21
Социальные сети


| Пн | Вт | Ср | Чт | Пт | Сб | Вс |